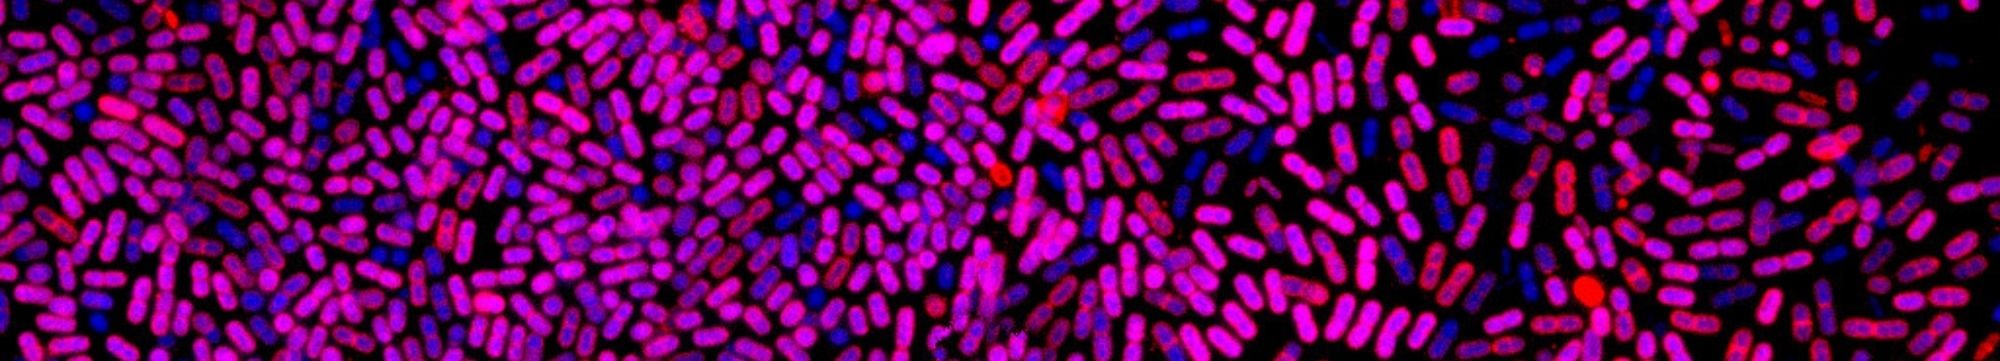
Bacterias ao microscopio con tinción gram (púrpura e azul)

Departamento de Oceanografía
El departamento estudia cómo funciona el océano desde el punto de vista físico, químico y biológico, poniendo el foco en los ciclos biogeoquímicos, su papel en el cambio global y el comportamiento del fitoplancton. Su trabajo abarca desde la biogeoquímica marina hasta la geoquímica orgánica y la fotobiología y toxinología del fitoplancton. Además, cuenta con valiosas series temporales, que van desde las rías gallegas hasta el Océano Atlántico y son clave para entender la evolución de estos sistemas.